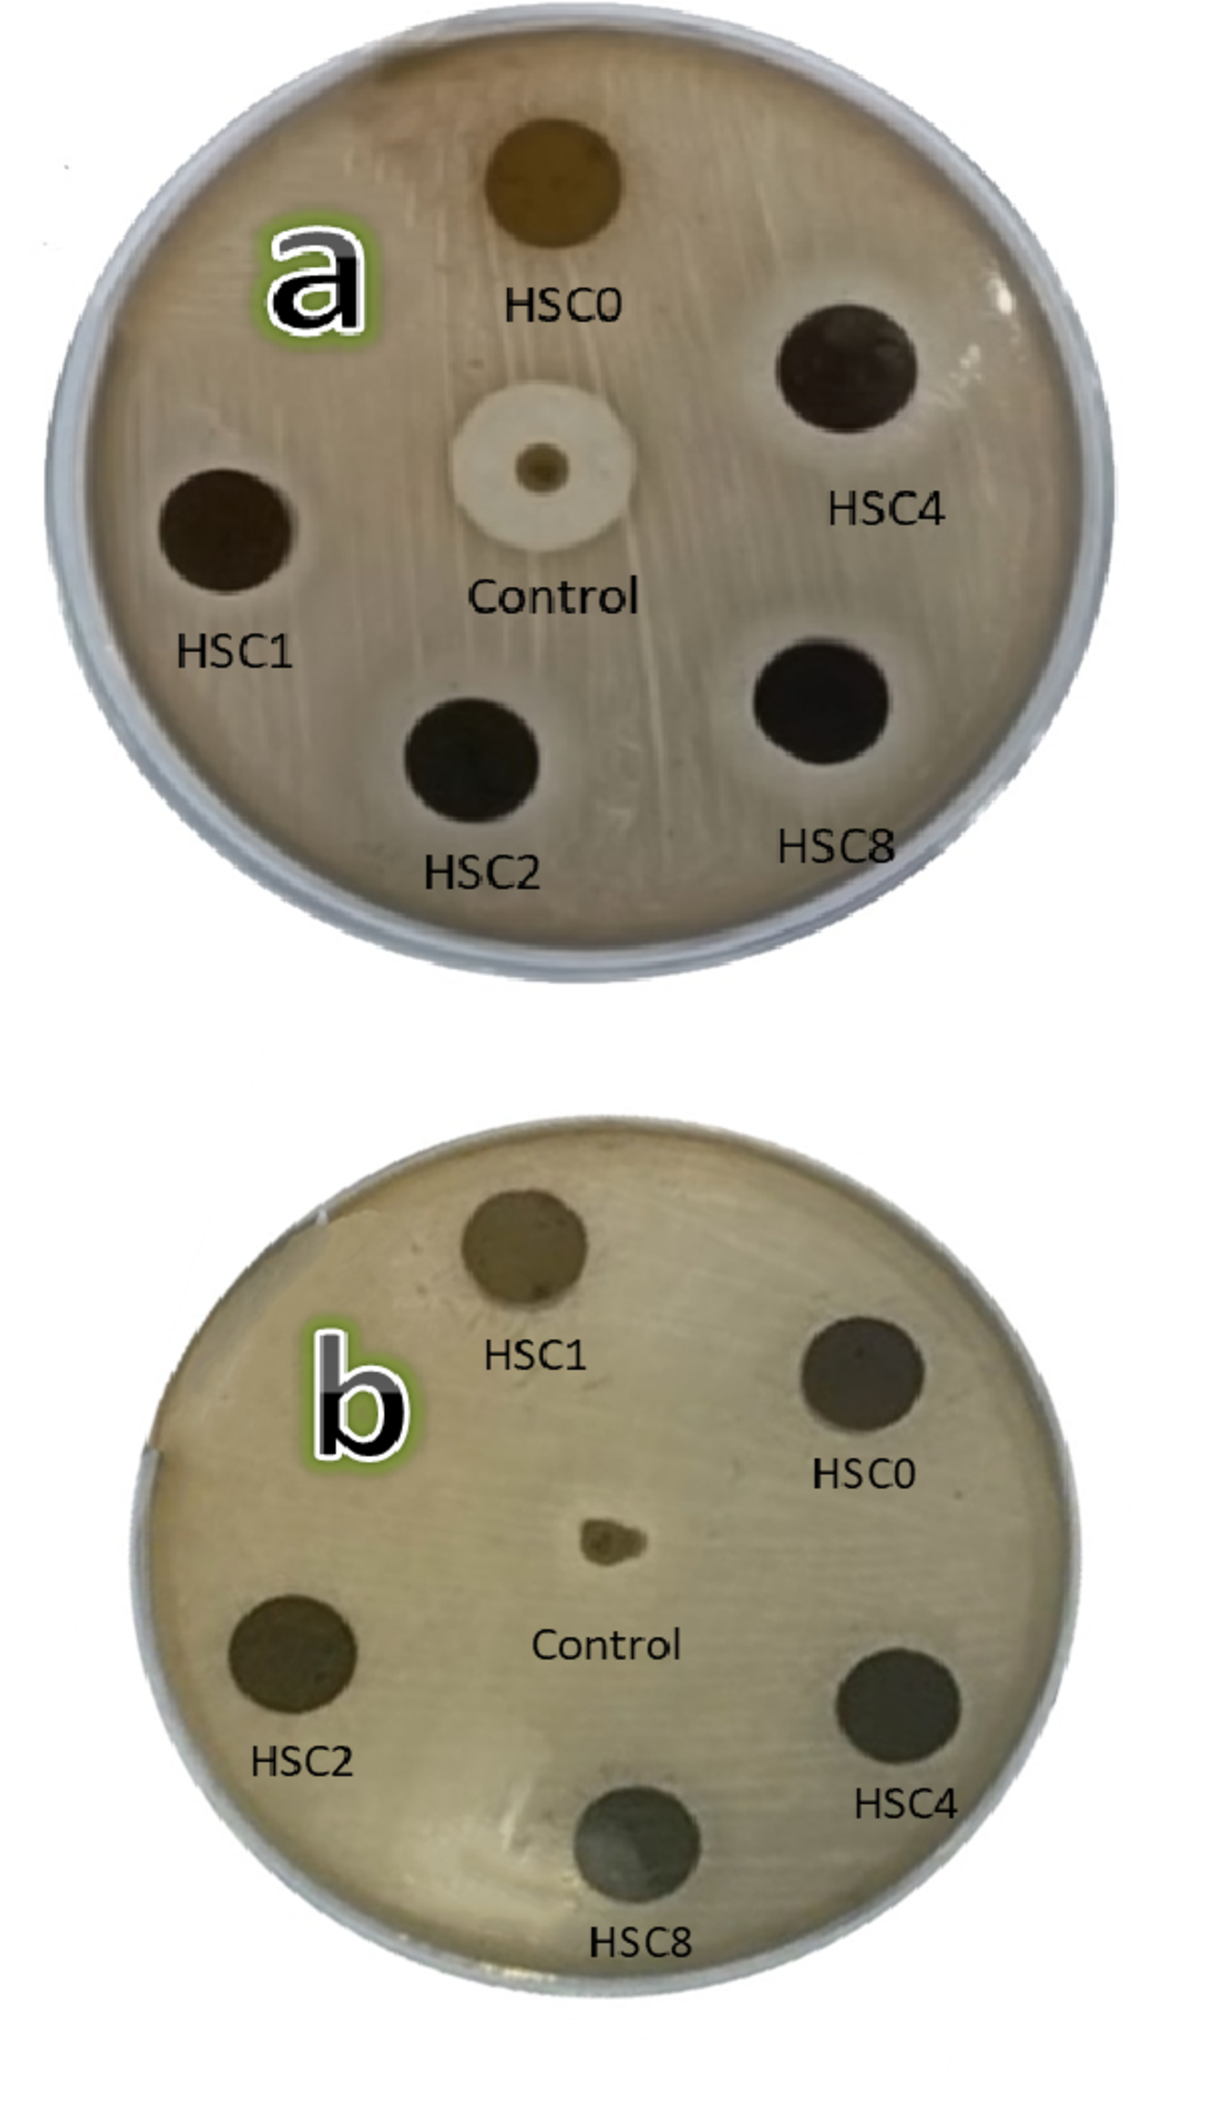
Fig. 19

Fig. 19

Photos of Petri dishes after conducting agar disc-diffusion assays against (a) S. aureus and (b) E. coli for sintered FGC layers.
Photos of Petri dishes after conducting agar disc-diffusion assays against (a) S. aureus and (b) E. coli for sintered FGC layers.